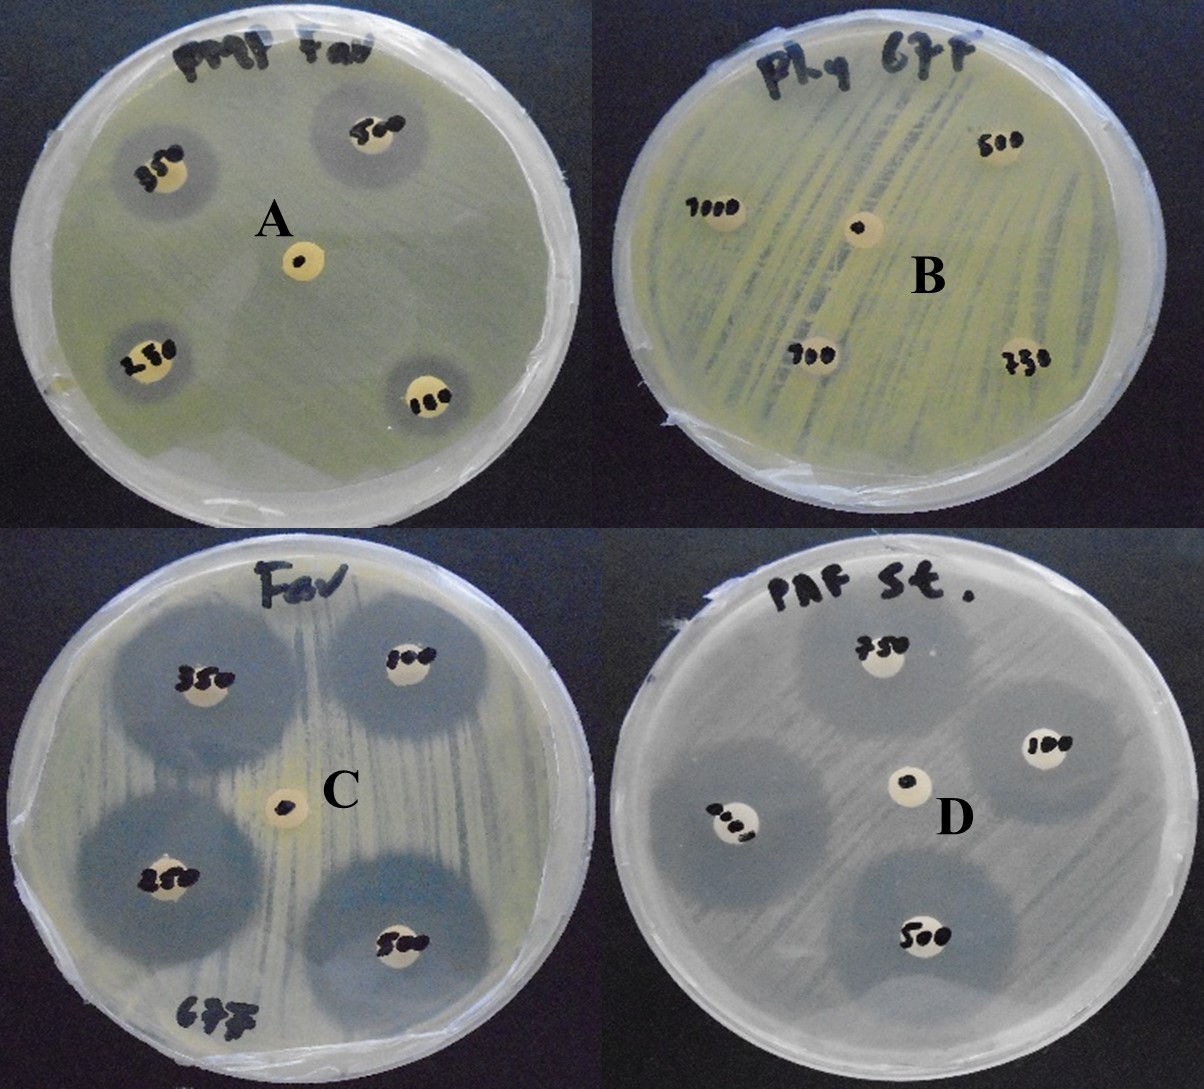
Halos de inhibici&oacute;n producidos por los bactericidas Clorhidrato  

de oxitetraciclina (A y C), &Aacute;cido oxol&iacute;nico (D),
Ausencia de inhibici&oacute;n  

bacteriana (B) por sulfato de cobre.

Ciencia de las plantas
Diagnóstico de enfermedades bacterianas en el cultivo de café (Coffea arabica L.) y sensibilidad in vitro a bactericidas de uso agrícola
Diagnosis of bacterial diseases in coffee cultivation (Coffea arabica L.) and in vitro sensitivity to bactericides for agricultural use
La Calera
Universidad Nacional Agraria, Nicaragua
ISSN: 1998-7846
ISSN-e: 1998-8850
Periodicidad: Semestral
vol. 23, núm. 40, 2023
Recepción: 29 Julio 2022
Aprobación: 02 Febrero 2023

Resumen: La producción de café está limitada por plagas que reducen las cosechas y disminuyen su calidad. Los objetivos de esta investigación fueron la identificación de bacterias fitopatógenas, descripción de síntomas en campo y sensibilidad in vitro a bactericidas de uso agrícola. Se seleccionaron cuatro fincas cafetaleras en el departamento de Jinotega y una en el departamento Matagalpa, con antecedentes de enfermedades bacterianas; las muestras de tejido colectadas consistieron en hojas, bandolas, frutos, y flores. La identificación de géneros de bacterias fitopatógenas se realizó a partir de características morfológicas de crecimiento bacteriano y presencia de pigmentos fluorescentes en King B. La identificación de especies de bacteria se realizó con prueba de oxidasa y pruebas de producción de ácidos a partir de carbohidratos. La patogenicidad de las bacterias se evaluó mediante la prueba de hipersensibilidad en plantas de tabaco (Nicotiana tabacum L.) como planta no huésped. La sensibilidad e inhibición de las bacterias a bactericidas se determinó mediante el método de Bauer-Kirby (método de difusión en agar) y fue evaluado en diámetros (mm). Los bactericidas evaluados fueron, clorhidrato de oxitetraciclina 5 WP, estreptomicina más oxitetraciclina 16. 5 WP, ácido oxolínico 20 WP y sulfato de cobre 24 SC. Las especies de bacterias identificadas fueron Pseudomonas syringae, Pseudomonas corrugata . Pseudomonas cichorii. En esta investigación Pseudomonas cichorii fue la más frecuente en los diferentes aislados, Pseudomonas syringae, fue aislada en todas las variedades de café muestreadas. Las especies de bacterias aisladas resultaron positivas a la prueba de hipersensibilidad, indicando ser patógenas para el cultivo de café. Los síntomas en hojas, bandolas y flores causados por Pseudomonas spp son manchas de coloración pardo-oscura, de forma y tamaño irregular, rodeada, generalmente por halos amarillentos y traslucidos. El bactericida que mostró mejor efecto al mostrar mayores diámetros en los halos de inhibición bacteriano fue el ácido oxolínico.
Palabras clave: Pseudomonas spp, bacteria, patogenicidad, hipersensibilidad.
Abstract: Coffee production is limited by pests, which reduce yields and lower quality. The objectives of this research were the identification of phytopathogenic bacteria, description of symptoms in the field and in vitro sensitivity to bactericides for agricultural use. Four coffee farms from the department of Jinotega and one from the department of Matagalpa, with a history of bacterial diseases, were selected; the tissue samples collected consisted of leaves, bandolas, fruits, and flowers. The identification of genera of phytopathogenic bacteria was carried out from the morphological characteristics of bacterial growth and the presence of fluorescent pigments in King B. The identification of bacteria species was carried out with an oxidase test and acid production tests from carbohydrates. The pathogenicity of the bacteria was evaluated by means of the hypersensitivity test in tobacco plants (Nicotiana tabacum L.) as a non-host plant. The sensitivity and inhibition of bacteria to bactericides was determined by the Bauer- Kirby method (agar diffusion method) and was evaluated in diameters (mm). The bactericides evaluated were oxytetracycline hydrochloride 5 WP, streptomycin plus oxytetracycline 16. 5 WP, oxolinic acid 20 WP and copper sulfate 24 SC. The species of bacteria identified were Pseudomonas syringae, Pseudomonas corrugata and Pseudomonas cichorii. In this investigation Pseudomonas cichorii was the most frequent in the different isolates, Pseudomonas syringae was isolated in all the coffee varieties sampled. The isolated bacterial species were positive to the hypersensitivity test, indicating that they are pathogenic for coffee cultivation. The symptoms on leaves, branchs and flowers caused by Pseudomonas spp are dark-brown spots, irregular in shape and size, generally surrounded by yellowish and translucent halos. The bactericide that showed the best effect by showing larger diameters in the bacterial inhibition halos was oxolinic acid.
Keywords: Pseudomonas spp, bacterium, pathogenicity, hypersensitivity.
El café es considerado un producto de importancia en la economía mundial y hasta el inicio de la crisis internacional del café, era el segundo producto con más valor en el mercado después del petróleo. Este grano se produce en más de 70 países alrededor del mundo, de estos 45 son miembros de la Organización Internacional del Café (OIC), que en su conjunto representan el 97 % de la producción mundial de café, según el Ministerio de Fomento Industria y Comercio (MIFIC, 2008).
En Nicaragua el café es cultivado por 44 000 productores en un área de 125 874 ha distribuidas en 10 departamentos, predominando el área de siembra en la zona norte del país. Constituye el primer producto de exportación llegando a alcanzar el 18 % total de las exportaciones, con una producción de 2 493 t. Genera el 53 % del empleo agropecuario nacional, el 21 % del PIB agrícola del país y el 2 % de PIB Nacional [Banco Central de Nicaragua, (BCN, 2017)].
Existe una diversidad de plagas insectiles y enfermedades que afectan a este cultivo y juegan un papel fundamental sobre la productividad y rentabilidad de las plantaciones. En las últimas décadas, en los cafetales centroamericanos y otras partes del mundo, se destacan enfermedades como roya del café, ojo de gallo y antracnosis (Avelino y Rivas, 2013). Actualmente la producción de café es mermada al igual que todos los cultivos, por las alteraciones de las condiciones climáticas, que se reflejan en el incremento de las temperaturas, sequias, inundaciones y cambios en los patrones del viento; estos eventos pueden causar cambios en el equilibrio de los agroecosistemas y favorecer el desarrollo de nuevas plagas.
En Brasil las enfermedades bacterianas causadas por el género Pseudomonas fueron detectadas por primera vez a finales de 1955 en cafetales del municipio de Garca, estado de Sao Paulo, incidiendo en hojas, bandolas y frutos. Los síntomas se caracterizan por ser manchas de coloración pardo-oscura, de forma y tamaño irregular, rodeada, generalmente por halos amarillentos (Costa y Silva, 1960). Las enfermedades de origen fungoso han predominado en el sistema café, en zonas cafetaleras de Nicaragua, no obstante, han sido reportada algunas especies de bacteria; como Pseudomonas cichorii Swingle 1925, indica el Instituto de Protección y Sanidad Agropecuaria (IPSA, 2016). Estas enfermedades han sido poco estudiadas y en muchas ocasiones la sintomatología es confundida por deficiencias de nutricionales.
Existe limitada información acerca de la etiología y características sintomatológicas, que ocasionan las bacterias fitopatógenas en este cultivo, así como las condiciones climáticas que favorecen su desarrollo. Para el manejo de estas enfermedades bacterianas en el cultivo del café, se ha incluido las aplicaciones de bactericidas como Estreptomicina + oxitetraciclina 16.5 WP, Estreptomicina 20 SP y Sulfato de cobre más oxitetraciclina 32 SC.
Actualmente entre los principales desafíos en el desarrollo de la caficultura nicaragüense, está el diagnóstico presuntivo de campo de las enfermedades bacterianas y el diagnóstico asertivo de la identificación de las especies bacterianas; utilizando métodos convencionales y moleculares para la respectiva identificación de especies y patovares. El propósito de esta investigación radica en la identificación de especies bacterianas, descripción de los síntomas asociados a las enfermedades que afectan el cultivo de café. Además de la determinación de la sensibilidad in vitro de algunos productos utilizados como bactericidas en el manejo de estas enfermedades. La información obtenida establecerá pautas para próximas investigaciones sobre el comportamiento y epidemiología de las enfermedades bacterianas en el cultivo del café en Nicaragua.
MATERIALES Y MÉTODOS
Tipo y ubicación del estudio
El estudio fue descriptivo y se desarrolló en dos etapas. En la primera etapa se colectó muestras de tejido vegetal enfermo en plantaciones de café en los departamentos de Matagalpa y Jinotega. La segunda etapa consistió en el procesamiento de las muestras en el laboratorio de microbiología vegetal de la Universidad Nacional Agraria, ubicado en el km 12 ½ de la Carretera Norte en Managua, cuyas coordenadas geográficas corresponden a 12°08’33” latitud Norte y 86°10’31” longitud Oeste.
Colecta de muestras
Las fincas cafetaleras fueron seleccionadas por presentar antecedentes de enfermedades bacterianas. En el departamento de Matagalpa fue seleccionada la finca El Limón, mientras que en Jinotega las fincas fueron El Cairo, El Palacio, Los Potrerillos y Santa Maura. Se colectó un total de 30 muestras de tejido vegetal enfermo, que incluyeron hojas, bandolas, flores y frutos. El tipo de colecta fue selectiva o dirigida en plantas con posibles síntomas de enfermedad bacteriana y se realizaron anotaciones acerca de las características morfológicas de los síntomas. En cada finca se levantó el historial del cultivo (área cultivada, variedades, edad de la plantación, manejo fitosanitario, otros manejos agronómicos, temperatura y altitud).
Descripción de síntomas de tejido vegetal enfermo
Se describieron los síntomas de muestras de tejido colectadas. Estas fueron observadas al estereoscopio y se seleccionaron muestras con características de manchas bacterianas y presencia de exudados bacterianos. Posteriormente se realizó el proceso de aislamiento e identificación de género y especie de bacteria (Raimundi, 2013; Rivero, 2017).
Identificación de bacterias fitopatógenas en tejido vegetal
El proceso de identificación de las bacterias fitopatógenas consistió en el aislamiento de las bacterias en tejido vegetal enfermo; se utilizó la técnica de inducción al crecimiento bacteriano. Se realizaron pruebas bioquímicas, para identificación de especies de bacterias y prueba de reacción de hipersensibilidad en plantas de tabaco (Nicotiana tabacum L.) por ser una especie no huésped de baterías que afectan al cultivo de café, y de esta mamera comprobar la patogenicidad de las bacterias identificadas.
Técnica de inducción al crecimiento bacteriano
La técnica de inducción al crecimiento para el aislamiento de bacterias de tejido vegetal enfermo consistió en la realización de cortes de 5 mm de tejido vegetal con síntomas de enfermedad bacteriana y se desinfectó con hipoclorito de sodio al 0.5 % y alcohol histológico al 95 %, posteriormente se lavó con agua destilada estéril y se realizó secado en superficie de papel filtro estéril, se sembró en cinco platos por muestra y cinco cortes por plato en medio agar nutritivo (AN). Finalmente, los platos se sellaron con Parafilm y rotulados con la debida información (Gutiérrez, 2012).
Identificación de géneros y especies de bacterias fitopatógenas mediante características morfológicas y pruebas bioquímicas
La identificación de géneros de bacterias fitopatógenas se realizó a partir cultivos puros de colonias bacterianas, con crecimiento de 24 horas; esta consistió, en observar las características morfológicas de crecimiento de colonias bacterianas que incluyen forma, color, aspecto y presencia de pigmentos fluorescentes en medio agar Pseudomonas (King B). Se realizaron las pruebas de hidróxido de potasio al 3 % (KOH al 3 %), oxidasa y Tinción Gram. Para identificación de especies se realizaron las pruebas de producción de ácidos a partir de sorbitol, celobiosa, trehalosa, sacarosa (Schaad, 2001).
Prueba de hipersensibilidad en planta no huésped
Para las pruebas de hipersensibilidad, se estableció un vivero de plántulas de tabaco. Las plántulas fueron inoculadas cuando alcanzaron un crecimiento entre 20 cm y 25 cm de altura. Por cada plántula se inoculó las bacterias previamente identificadas, un control positivo que consistió en la inoculación de Ralstoniasolanacearum obtenido del laboratorio de microbiología de la Universidad Nacional Agraria (UNA) y un control negativo que consistió en la infiltración agua destilada estéril.
Se preparó una suspensión bacteriana de 1 x10-8 a partir de cultivos puros con 48 horas de incubación. La inoculación se realizó en hojas totalmente expandidas, utilizando una jeringa hipodérmica, para infiltrar la suspensión bacteriana en los espacios intervenales. Las plántulas fueron irrigadas con agua destilada estéril y cubiertas con bolsas plásticas para crear condiciones de humedad. Se evaluó la reacción de hipersensibilidad positiva, mediante la observación de lesiones necróticas localizadas o la presencia de halos cloróticos amarillos a las 48 horas y 72 horas después de la inoculación (Raimundi, 2013).
Prueba de sensibilidad in vitro a bactericidas
Las bacterias que resultaron patogénicas fueron seleccionadas de acuerdo con la intensidad de la reacción de hipersensibilidad. Se utilizaron cuatro bactericidas de uso agrícola, estreptomicina más oxitetraciclina 16.5 WP, clorhidrato de oxitetraciclina 5 WP y ácido oxolínico 20 WP y sulfato de cobre 24 SC a diferentes dosis (Cuadro 1). Se utilizaron cuatro dosis por cada producto (dosis mínima de referencia, mínima recomendada, media y máxima recomendada en la etiqueta) con cinco repeticiones por dosis.
La dosis mínima de referencia es menor que la dosis mínima recomendada en la etiqueta del producto y se usó para conocer si las bacterias eran sensibles a esta dosis y de esta manera poder recomendarla para su utilización (Cuadro 1). Para la prueba de sensibilidad a antibióticos, se utilizó el método de Bauer et al, (1966). Este método consistió en preparar una suspensión bacteriana de turbidez 0.5 escala Mackfarland. Con un aplicador de madera punta de algodón humedecido con la suspensión bacteriana se inoculó el medio nutritivo (AN). Posterior a la inoculación se colocaron cuatro discos impregnados con los bactericidas a diferentes dosis y un disco impregnado con agua destilada estéril como testigo negativo.
Se realizó evaluación cualitativa de la sensibilidad a bactericidas en un periodo 24 horas. Consistió en la medición en milímetro del área o halo de inhibición de crecimiento bacteriano, causada por la dosis de bactericida como lo indica el Centro Nacional de Diagnóstico y Referencia (CNDR, 2004). Se consideran sensibles los aislados que no crecieron alrededor del disco impregnado con el bactericida produciendo halos de inhibición mayores de 14 mm, y resistentes los aislados bacterianos que presentaron crecimiento bacteriano alrededor del disco impregnados con el bactericida, mostrando halos de inhibición menores de 14 mm [Clinical and Laboratory Standards Intitute (CLSI, 2016)].
| Bactericida | Dosis (g 200 L-1) | |||
| Referencia | Mínima | Media | Máxima | |
| Estreptomicina + oxitetraciclina 16.5 WP | 100 | 240 | 260 | 280 |
| Clorhidrato de oxitetraciclina 5 WP | 100 | 250 | 350 | 500 |
| Ácido oxolínico 20 WP | 100 | 500 | 750 | 1000 |
| Sulfato de cobre 24 SC | 100 | 500 | 750 | 1000 |
WP: Polvo humectable, SC: Solución concentrada.
Análisis de datos
La información obtenida fue analizada de manera descriptiva. Los datos de sensibilidad a bactericidas fueron organizados en una base de datos en Microsoft Excel, luego fueron analizados con el programa estadístico InfoStat, en donde se realizó un análisis de varianza (ANDEVA) y separación de medias con la prueba de Tukey (α= 0.05).
RESULTADOS Y DISCUSIÓN
Características de fincas cafetaleras en estudio
El área de las fincas donde se colectaron las muestras es mayor a 60 ha de café. El nivel tecnológico en relación con el uso de insumos es alto, en sistema de producción agroforestales. La fertilización está basada en análisis químico de suelo, manejo integrado de plagas, así como la aplicación de buenas prácticas agrícolas . La temperatura promedio en las fincas es de 25 ºC y la altitud promedio de 1 068 msnm. Generalmente estas fincas tienen establecido variedades de café Parainema, Marsellesa, Caturra, Pacamara y Catuaí. Las variedades establecidas en las fincas son adecuadas para las condiciones agroclimáticas.
Síntomas en tejido vegetal causados por el género Pseudomonas
Los síntomas en hojas causados por Pseudomonas, se observaron cómo manchas de coloración pardo-oscura, de forma irregular y rodeada por halo acuoso amarillo y traslucido, frecuentemente asociadas con manchas necróticas causadas por el complejo de hongos; Cercospora coffeicola (Berk & Cooke), Hemileia vastatrix (Berkeley & Broome) y Mycena citricolor (Berkeley & Curtis). En algunas muestras los síntomas se observaron manchas necróticas extendidas a lo largo de las nervaduras de las hojas (Figura 1). En bandolas se observaron manchas necróticas de forma irregular; generalmente las manchas se observaron en los entrenudos de las bandolas. En los brotes florales los síntomas fueron manchas pequeñas de coloración pardo-oscura, de forma y tamaño irregular (Figura 2).


Rivero (2013) relaciona el daño de P. syringae con manchas foliares necróticas irregulares, de coloración marrón, rodeadas por un halo amarillento que pueden coalescer, formando grandes áreas necrosadas; reporta que los síntomas ocasionados por las diferentes especies de Pseudomonas a nivel de campo no mostraron diferenciación entre ellos, lo que dificulta su caracterización a nivel de especie.
Según Raimundi (2013), Rivero (2017), las diferentes especies bacterianas patógenas del café producen síntomas similares, razón por la cual la identificación de P. cichorii y P. syringae debe realizarse mediante pruebas bioquímicas y moleculares.
Identificación de bacterias fitopatógenas en tejido vegetal
Las bacterias identificadas en las diferentes variedades de café mediante pruebas bioquímicas fueron Pseudomonas cichorii, Pseudomonas syringae y Pseudomonas corrugata. Estas mostraron reacciones positivas a la reacción con KOH 3 % y morfología de bacilos Gram negativos al observarlos al microscopio óptico con tinción Gram. La especie P. cichorii predominó en los crecimientos bacterianos, mientras que las especies P. syringae, se identificó en todas las variedades. La especie de P. corrugata, se identificó en las variedades Pacamara y Caturra (Cuadro 2). Las especies de P. syringae y P. cichorii produjeron pigmentación en el medio nutritivo y King B, la prueba de oxidasa fue positiva para las especies P. cichorii y P. corrugata, mientras que para P. syringae fue negativa. En el caso de las pruebas de carbohidratos P. syringae fue la que mostró capacidad de fermentar la Sacarosa y Trehalosa (Cuadro 3).
| Variedades de café | Bacterias | ||
| P. syringae | P. cichorii | P.corrugata | |
| Parainema | 3 | 5 | 0 |
| Marsellesa | 1 | 4 | 0 |
| Caturra | 1 | 4 | 3 |
| Pacamara | 1 | 2 | 1 |
| Catuaí | 1 | 0 | 0 |
| Total | 7 | 15 | 4 |
| Aislado | T.Gram | KOH | Oxi | Cel | Sac | Sor | Trea | Benz | Género-especie |
| PAF | Bacilo G- | + | - | - | + | - | + | Pseudomonas syringae | |
| PBP1 | Bacilo G- | + | - | - | - | - | + | Pseudomonas corrugata | |
| BPP2 | Bacilo G- | + | - | - | - | - | + | Pseudomonas corrugata | |
| PMP | Bacilo G- | + | - | - | + | - | + | Pseudomonas syringae | |
| 4A | Bacilo G- | + | + | - | - | - | - | - | Pseudomonas cichorii |
| 11 | Bacilo G- | + | + | - | + | - | + | Pseudomonas corrugata | |
| 6 | Bacilo G- | + | + | - | - | - | + | Pseudomonas corrugata | |
| 16 | Bacilo G- | + | + | - | - | - | - | - | Pseudomonas cichorii |
| 10 | Bacilo G- | + | + | - | - | - | - | - | Pseudomonas cichorii |
| 30 | Bacilo G- | + | - | - | + | - | + | Pseudomonas syringae | |
| 29 | Bacilo G- | + | + | - | - | - | - | - | Pseudomonas cichorii |
| 31 | Bacilo G- | + | + | - | - | - | - | - | Pseudomonas cichorii |
| 33 | Bacilo G- | + | + | - | - | - | - | - | Pseudomonas cichorii |
| 41 | Bacilo G- | + | - | - | + | - | - | Pseudomonas syringae | |
| 52 | Bacilo G- | + | + | - | - | - | - | - | Pseudomonas cichorii |
| 64 | Bacilo G- | + | + | - | - | - | - | - | Pseudomonas cichorii |
| 67F | Bacilo G- | + | + | - | - | - | - | - | Pseudomonas cichorii |
| 69 | Bacilo G- | + | + | - | - | - | - | - | Pseudomonas cichorii |
| 60 | Bacilo G- | + | + | - | - | - | - | - | Pseudomonas cichorii |
| 66 | Bacilo G- | + | + | - | - | - | - | - | Pseudomonas cichorii |
| 54 | Bacilo G- | + | + | - | - | - | - | - | Pseudomonas cichorii |
| 62 | Bacilo G- | + | - | - | + | - | - | Pseudomonas syringae | |
| 89 | Bacilo G- | + | + | - | - | - | - | - | Pseudomonas cichorii |
| 96 | Bacilo G- | + | - | - | + | - | - | Pseudomonas syringae | |
| 82 | Bacilo G- | + | + | - | - | - | - | - | Pseudomonas cichorii |
| 71 | Bacilo G- | + | + | - | - | - | - | - | Pseudomonas cichorii |
| 80 | Bacilo G- | + | + | - | - | - | - | - | Pseudomonas cichorii |
T.Gram: Tinción Gram, KOH: Hidróxido de potasio, (Oxi: Oxidasa, Cel: Celobiosa, Sac: Sacarosa, Sor: Sorbitol, Tre: Trehalosa, Benz: Benzoato, Símbolo (-): Negativo, Símbolo (+): Positivo, G: Gram.
Estudio realizado por Raimundi (2013) en relación con el diagnóstico de enfermedades bacterianas en el cultivo de café identificó mediante técnicas convencionales a las especies de P. syringae y P. cichorii en las variedades Catuaí y Mundo Nuevo. Otras investigaciones hacen referencia a la identificación de la especie P. syringae mediante morfología y crecimiento en medios cultivos selectivos, a partir de hojas de café (Rivero, 2017; Zoccoli et al., 2011).
Prueba de reacción de hipersensibilidad en planta no huésped
Los aislados bacterianos identificados como de P. syringae, P. cichorii y P. corrugata, mostraron resultados positivos a la prueba de hipersensibilidad en tabaco, indicando patogenicidad para el cultivo de café (Figura 3). Estos resultados fueron similares a los obtenidos por Raimundi (2013), Belan et al. (2016), Rivero (2017), que determinaron la patogenicidad de las especies de Pseudomonas cichorii y syringae aisladas de tejido de café e inoculadas en hojas de plantas de tabaco. La especie P. corrugata no ha sido reportada afectando el cultivo de café, sin embargo, se ha registrado su patogenicidad en algunas solanáceas como tomate, tabaco, pimiento y berenjena (Silverio y López, 1994).

Sensibilidad de bacterias fitopatógenas a bactericidas de uso agrícola
Se seleccionaron nueve aislados bacterianos tomando como criterio de selección la intensidad de la reacción en la prueba de hipersensibilidad en tabaco. Los aislados seleccionados fueron cuatro de P. cichorii, tres de P. syringae y dos de P. corrugata. Los antibióticos estreptomicina + oxitetraciclina 16.5 WP inhibió el crecimiento de los aislados bacterianos Pseudomonas cichorii (67F), Pseudomonas corrugata (PBP), Pseudomonas syringae (PAF). Sin embargo, no inhibió el crecimiento en los asilados bacterianos Pseudomonas cichorii (4A, 29B). El ácido oxolínico 20WP inhibió el crecimiento de los aislados bacterianos Pseudomonas cichorii (4A), Pseudomonas corrugata (PBP); sin embargo, no inhibió el crecimiento en los asilados bacterianos Pseudomonas cichorii (67F, 71C).
Clorhidrato de oxitetraciclina 5 WP inhibió el crecimiento de los aislados bacterianos Pseudomonas cichorii (67F), Pseudomonas syringae (PAF), sin embargo, no inhibió el crecimiento en los asilados bacterianos Pseudomonas cichorii (29B), Pseudomonas corrugata (PBP2). Sulfato de Cobre 24 SC no inhibió el crecimiento bacteriano del género Pseudomonas, indicando que las bacterias son resistentes al producto (Cuadro 4, Figura 4).
| Aislado | Bacteria identificada | Resultados de las pruebas | |||
| Estreptomicina + oxitetraciclina | Oxitetraciclina | Ácido Oxolínico | Sulfato de cobre | ||
| 71C | P. cichorii | Sensible | Sensible | Resistente | Resistente |
| 67F | P. cichorii | Sensible | Sensible | Resistente | Resistente |
| 29B | P. cichorii | Resistente | Resistente | Sensible | Resistente |
| 96D | P. syringae | Sensible | Sensible | Sensible | Resistente |
| PMP | P. syringae | Sensible | Sensible | Sensible | Resistente |
| PBP2 | P.corrugata | Sensible | Resistente | Sensible | Resistente |
| PAF | P syringae | Sensible | Sensible | Sensible | Resistente |
| PBP | P.corrugata | Sensible | Sensible | Sensible | Resistente |
| 4A | P. cichorii | Resistente | Sensible | Sensible | Resistente |
Sensibilidad: No hay crecimiento alrededor del disco, Resistencia: Hay crecimiento alrededor del disco, no hay presencia de halo de inhibición
Schauffler y Di Piero (2017) determinaron que la dosis de 10 mg ml-1 de estreptomicina + oxitetraciclina usado como testigo en Pseudomonas syringae aislada de tomate, presentó halos de inhibición de 16.2 mm, resultando sensible a dicho producto. Scheck y Pscheidt (1998) estudió cepas de P. syringae, pv. Syringae aisladas de plantas ornamentales y registró resistencia a estreptomicina y sulfato de cobre (CuSO4) en ensayos in vitro. Zoccoli et al. (2011) indica que la posibilidad de que ocurran interacciones adversas entre metales como el cobre y el medio de cultivo son muy alta, existe la posibilidad de que en el medio de cultivo el cobre no esté disponible, lo que puede llevar a resultados inconclusos.
Análisis de sensibilidad a bactericidas
Las dosis de 240 g 200 L-1, 260 g 200 L-1 y 280 g 200 L-1 superaron la dosis de referencia de 100 g 200 L-1 para el caso de estreptomicina más oxitetraciclina (Figura 5); mientras que en el ácido oxolínico las dosis de 500 g 200 L-1, 750 g 200 L-1 y 1 000 g 200 L-1 superan a la dosis de referencia de 100 g 200 L-1 que produjo menores halos de inhibición (Figura 6). Los mejores resultados, para el caso de clorhidrato de oxitetraciclina se observaron en las dosis de 350 g 200 L-1 y 500 g/200 L-1 (Figura 7). En este estudio los datos de sensibilidad para sulfato de cobre no se ajustaron al modelo estadístico por no mostrar halos de inhibición, además se demuestra que las dosis mínimas para los productos estreptomicina más oxitetraciclina, ácido oxolínico y clorhidrato de oxitetraciclina producen los mismos efectos inhibitorios que las dosis máximas recomendadas para cada producto. El bactericida con ingrediente activo ácido oxolínico mostró mayor efecto de inhibición en el crecimiento bacteriano.



McManus y Jones (1994) afirman que la oxitetraciclina tiene un efecto bacteriostático y es menos efectiva que la estreptomicina, que tiene efecto bactericida, pero esta es más efectiva cuando se aplica para el manejo de cepas bacterianas que son resistentes a la estreptomicina.
CONCLUSIONES
El género Pseudomonas spp fue el causante de enfermedades bacterianas en el cultivo de café, afectando principalmente hojas, bandolas y flores. Los síntomas se caracterizan por ser manchas de coloración pardo-oscura, de forma y tamaño irregular, rodeada, generalmente por halos acuosos y traslucidos.
Se identificaron especies de bacterias del género Pseudomonas, tales como Pseudomonas cichorii, Pseudomonas. syringae y Pseudomonas corrugata, determinando que son patógenas para el cultivo de café.
Las dosis mínimas para los productos estreptomicina más oxitetraciclina, ácido oxolínico y clorhidrato de oxitetraciclina producen los mismos efectos inhibitorios que las dosis máximas recomendadas para cada producto. El efecto inhibitorio fue visible sobre el crecimiento bacteriano de los aislados Pseudomonas syringae y Pseudomonas corrugata, sin embargo, no inhibieron el crecimiento bacteriano de los aislados Pseudomonas cichorii y el bactericida que mostró mayor efecto de inhibición en el crecimiento bacteriano fue el ácido oxolínico 20 WP.
Agradecimientos
A los productores cafetaleros que permitieron el desarrollo de esta investigación, a la Ingeniera Patricia Contreras Estradas por los conocimientos y tiempo brindado y al Departamento de Protección Agrícola y Forestal de la Universidad Nacional Agraria.
REFERENCIAS BIBLIOGRÁFICAS
Avelino, J. y Rivas, G. (2013). La roya anaranjada del cafeto. https://www.researchgate.net/publication/260789530_La_roya_anaranjada_del_cafeto
Banco Central de Nicaragua. (2017). Informe Anual 2017. https://www.bcn.gob.ni/sites/default/files/documentos/1.Informe%20Anual%202017.pdf
Bauer, A. W., Kirby, W. M., Sherris, J. C. y Turck, M. (1966). Antibiotic susceptibility testing by a standardized single disk method. American Journal of Clinical Pathology, 45(4), 493-496. https://doig.org/10.1093/ajcp/45.4_ts.493
Belan, L. L., Pozza, E. A., de Oliveira Freitas, M. L., Raimundi, M. K., de Souza, R. M., & da Cruz Machado, J. (2016). Occurrence of Pseudomonas syringae pv. garcae in coffee seeds. Australian Journal of Crop Science, 10(7), 1015-1021. https://doi.org/10.21475/ajcs.2016.10.07.p7693
Centro Nacional de Diagnóstico y Referencia. (2004). Manual de procedimientos de bacteriología médica. CNDR.
Clinical and Laboratory Standards Institute. (2016). Performance standards for antimicrobial susceptibility testing. CLSI.
Costa, A. S. y Silva, D. M. A. (1960). Estudos sobre mancha aureolada do cafeeiro, Campinas. Bragantia, 19, 63-69. https://www.scielo.br/j/brag/a/QJkFxrXp5N7yg6nH9hrN84J/?format=pdf&lang=pt
Gutiérrez, Y. (2012). Módulo práctico: técnicas de laboratorio. Universidad Nacional Agraria.
Instituto de Protección y Sanidad Agropecuaria. (2016). Lista de plagas reglamentadas, Nicaragua 2016. https://www.ipsa.gob.ni/Portals/0/4%20Sanidad%20Vegetal%20y%20Semillas/Listado%20de%20Plagas%20cuarentenarias%20en%20Nicaragua%20Versi%C3%B3n%20I%20marzo%20de%202016.pdf
McManus, P. y Jones, A. (1994). Epidemiology and genetic analysis of streptomycin-resistant Erwinia amylovora from Michigan and evaluation of oxytetracycline for control. Phytopathology, 84(6), 627-633. https://www.apsnet.org/publications/phytopathology/backissues/Documents/1994Articles/Phyto84n06_627.PDF
Ministerio de Fomento Industria y Comercio. (2008). Ficha producto “café”. https://cenida.una.edu.ni/documentos/NE71N583fc.pdf
Raimundi, M, K. (2013). Caracterização e identificação de isolados bacterianos patogênicos ao cafeeiro [Tesis de maestría, Universidad Federal de Lavras]. Repositorio UFLA. http://repositorio.ufla.br/jspui/handle/1/1737
Rivero, L. M., Gatti, I. M., Alves, F. R., Saggion, L. O., Wolf, K., Toma, M. y Guerreiro, O. (2013). Mancha aureolada do cafeeiro causada por Pseudomonas syringae pv. Garcae. Instituto Agronômico. https://www.iac.sp.gov.br/publicacoes/arquivos/iacbt212.pdf
Rivero, L. M., Hiroshi, G., Guerreiro, F., Saggion, L. O. y Gatti, I. M. (2017). First report of mixed infection by Pseudomonas syringae pathovars garcae and tabaci on coffee plantations. Bragantia, 76(4), 850-855. https://doi.org/10.1590/1678-4499.2016.399
Schaad, N. W., Jones, J. B., & Chun, W. (2001). Laboratory guide for the identification of plant pathogenic bacteria, Third Edition. Plant Pathology, 50(6), 812-814. https://doi.org/10.1046/j.1365-3059.2001.00635.x
Schauffler, G. P. y Di Piero, R. M. (2017). Extratos de própolis no controle da mancha bacteriana (Xanthomonas gardneri) e da pinta bacteriana (Pseudomonas syringae) em tomateiro [Trabajo de graduación, Universidad federal de Santa Catarina]. Repositorio Institucional UFSC. https://repositorio.ufsc.br/xmlui/handle/123456789/174321
Scheck, H. J., & Pscheidt, J. W. (1998). Effect of copper bactericides on copper-resistant and -sensitive Strains of Pseudomonas syringae pv. syringae. Plant Disease, 82(4), 397-406. https://apsjournals.apsnet.org/doi/pdf/10.1094/PDIS.1998.82.4.397
Silverio, F. y López, M. (1994). Patogenicidad de Pseudomonas corrugata sobre tomate, pimiento y otras especies de interés agrícola. En Pseudomonas corrugata roberts y scarlett, agente causal de la necrosis medular del tomate (pp. 136-159). https://www.researchgate.net/publication/325169600_Patogenicidad_de_Pseudomonas_corrugata_sobre_tomate_pimiento_y_otras_especies_de_interes_agricola
Zoccoli, D. M., Takatsu, A. y Uesugi, C. H. (2011). Ocorrência de mancha aureolada em cafeeiros na Região do Triângulo Mineiro e Alto Paranaíba. Bragantia, 70(84), 843-849. https://www.scielo.br/j/brag/a/PHxKNTPL8cnMR4dfqxtT8Ld/?lang=pt&format=pdf
Notas de autor

